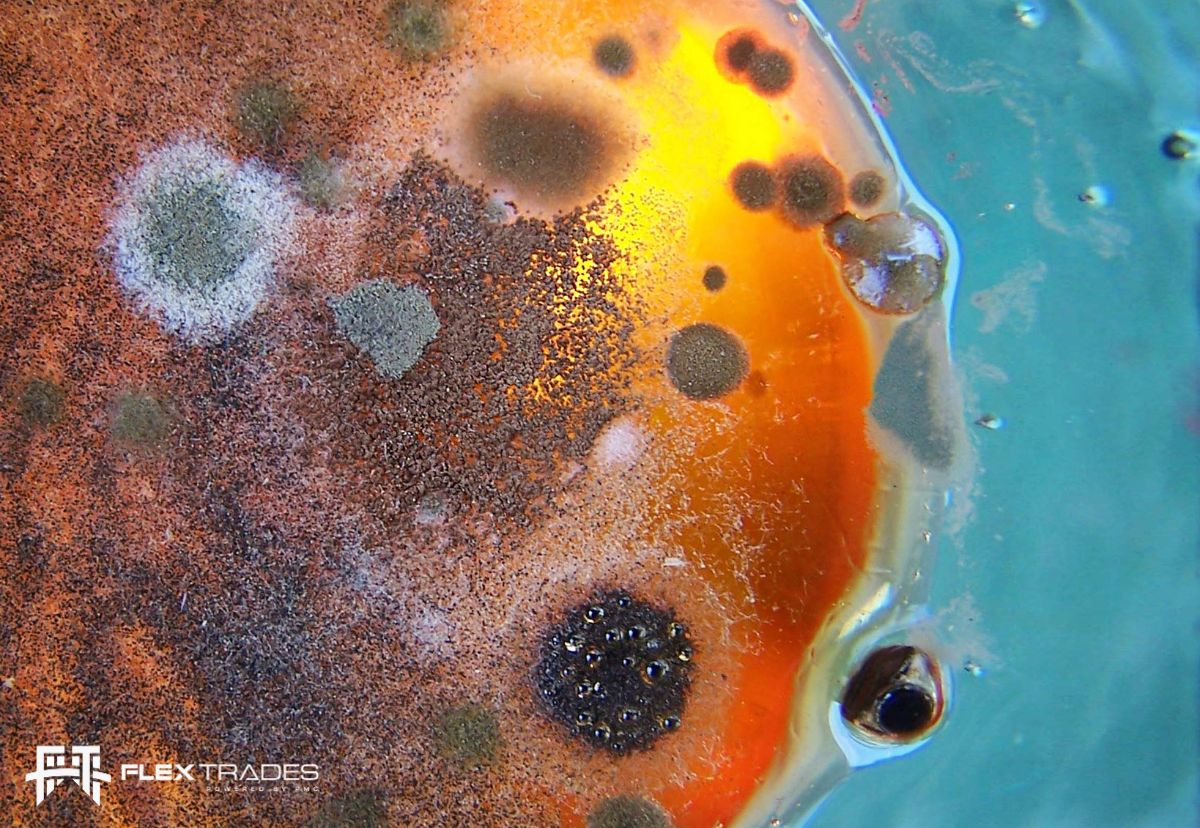
Mold Repair Technicians

FlexTrades recently assigned one of our skilled Tool/Mold Repair Technicians, Kelly, to assist a steel processing client. At the beginning of the assignment, the client was facing a significant issue with a 39% downtime in their production due to mold repair inefficiencies. Over a span of 4 months, Kelly made remarkable progress by reducing this downtime to 19%. During the remainder of his 8-month tenure, Kelly continued to make impressive improvements, ultimately achieving a remarkable reduction in downtime to just 13%. This substantial enhancement in productivity can be attributed to Kelly’s multi-faceted abilities, including efficient mold repair, as well as his capacity to train and oversee eight less-experienced mold technicians within the client’s workforce.
Learn more about how FlexTrades Tradespeople can help your downtime.